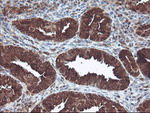
CNDP2 Antibody in Immunohistochemistry (Paraffin) (IHC (P))

Search
OriGene
CNDP2 Monoclonal Antibody (OTI8A2), TrueMAB™
{{$productOrderCtrl.translations['antibody.pdp.commerceCard.promotion.promotions']}}
{{$productOrderCtrl.translations['antibody.pdp.commerceCard.promotion.viewpromo']}}
{{$productOrderCtrl.translations['antibody.pdp.commerceCard.promotion.promocode']}}: {{promo.promoCode}} {{promo.promoTitle}} {{promo.promoDescription}}. {{$productOrderCtrl.translations['antibody.pdp.commerceCard.promotion.learnmore']}}
产品信息
TA503168
种属反应
宿主/亚型
分类
类型
克隆号
抗原
偶联物
形式
浓度
纯化类型
保存液
内含物
保存条件
运输条件
靶标信息
The CNDP2 gene encodes the protein carnosine dipeptidase 2, which belongs to the M20 metallopeptidase family and plays a critical role in the metabolism of dipeptides. CNDP2 is primarily involved in the hydrolysis of carnosine, a dipeptide composed of beta-alanine and histidine, and is expressed in various tissues, including the liver and kidney. This enzyme is significant in cellular processes related to nitrogen metabolism and the regulation of histidine-containing dipeptides, which have antioxidant properties influencing cellular redox balance. CNDP2 has implications in renal function and disease, where altered activity can impact the concentration of bioactive peptides involved in protective mechanisms against oxidative stress. Additionally, CNDP2 may have roles in metabolic diseases, such as diabetes and hypertension, where dipeptide regulation can influence metabolic pathways and cellular protection mechanisms. Ongoing research explores CNDP2's enzymatic activity, regulation, and potential therapeutic applications, particularly in conditions where modulation of peptide metabolism can offer clinical benefits.
仅用于科研。不用于诊断过程。未经明确授权不得转售。
篇参考文献 (0)
生物信息学
蛋白别名: carnosine dipeptidase II; CNDP dipeptidase 2; Cytosolic non-specific dipeptidase; cytosolic nonspecific dipeptidase; epididymis secretory protein Li 13; Glutamate carboxypeptidase-like protein 1; Peptidase A; Threonyl dipeptidase
基因别名: CN2; CNDP2; CPGL; HEL-S-13; HsT2298; PEPA
UniProt ID: (Human) Q96KP4
Entrez Gene ID: (Human) 55748